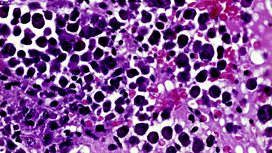

Cancer Breakthrough and Apple v the FBI
Jeremy discusses a cancer breakthrough, Jason Lawrance the so called "Match.com rapist", the damage caused by diesel and Apple take on the FBI over privacy and security.
Last on
![]()
On Jeremy Vine today
Cancer breakthrough, Jason Lawrance, the damage caused by diesel & Apple take on the FBI
![]()
Get in Touch With The Show
Phone, text or email us your views
![]()
Cure For Cancer?
Scientists say they might have found a cure for cancer using the body's immune system.
![]()
Jason Lawrance
Jason Lawrance met and raped five women via match.com. How dangerous can dating sites be?
![]()
The Damage Caused by Diesel
How much diesel pollution do we breathe in on a daily basis?
![]()
Apple's FBI fight
Apple refuses to develop software to hack into a terrorist's iPhone. We hear the latest.
Music Played
![]()
Seal
Crazy
- The Hit Pack (Various Artists).
- CBS.
- 4.
![]()
a-ha
Objects In The Mirror
- (CD Single).
- Universal.
![]()
Train
Drops Of Jupiter (Tell Me)
- (CD Single).
- Columbia.
![]()
Semisonic
Chemistry
- (CD Single).
- MCA.
![]()
Fiction Factory
(Feels Like) Heaven
- Fantastic 80's - 3 (Various Artists).
- Sony Tv/Columbia.
![]()
Bellowhead
Roll The Woodpile Down
- Broadside.
- Navigator Records.
- 003.
![]()
Blondie
Call Me
- Atomic: The Very Best Of Blondie.
- EMI.
![]()
James Morrison
I Need You Tonight
- Higher Than Here.
- Island.
- 001.
![]()
The Hollies
The Air That I Breathe
- The Gold Album (Various Artists).
- The Hit Label Ltd.
- 14.
![]()
Elvis Presley & Royal Philharmonic Orchestra
If I Can Dream
- If I Can Dream.
- RCA.
- 14.
![]()
Simple Minds
Don't You (Forget About Me)
- Glittering Prize - Best Of Simple Min.
- Virgin.
Broadcast
- Fri 4 Mar 201612:00BBC Radio 2